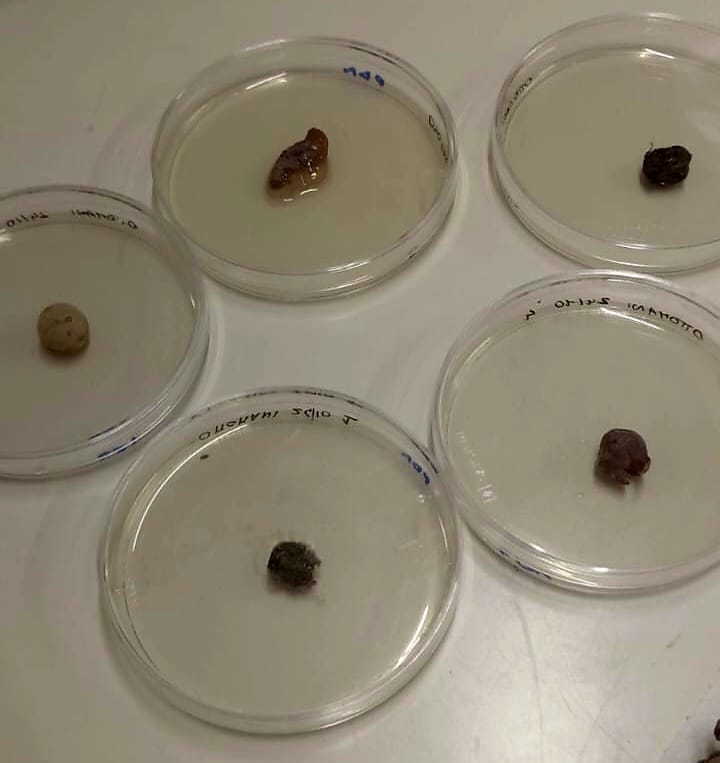

Proseguono le attività del progetto SeLiProVi – Selezione di lieviti autoctoni per la produzione di vini passiti, progetto di cooperazione finanziato tramite l’intervento realizzato con cofinanziamento FEASR del Piano Sviluppo Rurale 2024/2022 della Regione Toscana sottomisura 16.2.
L’obiettivo del progetto è quello di ottimizzare il processo di produzione dei vini passiti realizzati dalle due aziende partner del progetto.
Prosegue l’appassimento delle uve per la produzione del Vin Santo Riseccoli e del vino da vendemmia tardiva di uve stramature Ottomani. A breve saranno allestiti i nuovi caratelli.


Prosegue inoltre il piano sperimentale di selezione dei lieviti che verranno usati per la vendemmia 2024.
Di seguito uno schema esplicativo che sintetizza il piano sperimentale di selezione dei lieviti, a partire dall’isolamento di un vasto numero di lieviti da quattro fermentazioni spontanee, fino alla selezione dei ceppi di lievito utili alla vendemmia 2024.


Intervento realizzato con cofinanziamento FEASR del Piano di Sviluppo Rurale 2014 – 2022 della Regione Toscana sottomisura 16.2 Cup Artea 1074119
